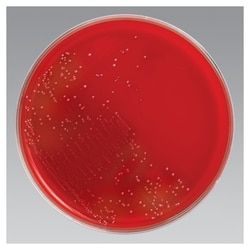
Img

R01304
Thermo Scientific™ Chocolate Agar w/Bacitracin
Manufacturer: Thermo Scientific™
Select a Size
| Pack Size | SKU | Availability | Price |
|---|---|---|---|
| Pack of 10 | R01304-Pack-of-10 | In Stock | ₹ 11,392.00 |
R01304 - Pack of 10
In Stock
Quantity
1
Base Price: ₹ 11,392.00
GST (18%): ₹ 2,050.56
Total Price: ₹ 13,442.56
Description
Chocolate Agar w/Bacitracin
Format
12mm x 85mm Monoplate
Product Type
Agar
Quantity
10/Pk.
Related Products
Description
- Isolate Haemophilus species from respiratory specimens containing mixed flora with Thermo Scientific™ Remel™ Chocolate Agar w/Bacitracin
- Isolation and identification of Haemophilus spp is often hindered by overgrowth with commensal microbial flora
- Hoving and Aandahl reported improved recovery of Haemophilus on Chocolate Agar with Bacitracin as compared to isolation on Sheep Blood Agar with a streak of Staphylococcus aureus
- Hemoglobin in the Chocolate Agar formulation provides the X factor, and GCHI Enrichment provides the V factor required for growth of fastidious organisms
- The presence of corn-starch ensures that toxic metabolites produced Haemophilus by are absorbed
- Bacitracin is a selective agent which is inhibitory to most strains of streptococci, staphylococci, Neiseeria spp., and Micococcus spp
- Not all products are available for sale in all territories
- Please inquire
- Remel™ and Oxoid™ products are now part of the Thermo Scientific brand.